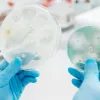

A fruticultura tem se consolidado como uma das atividades mais promissoras do agronegócio goiano. Com terra e clima favoráveis, esse mercado vem se ampliando significativamente nos últimos anos com a conquista de espaço até no mercado internacional. Um das contribuições importantes para o desenvolvimento da fruticultura no...

Na manhã desta quarta-feira, 27, a Spaço Agrícola Tepeyac promoveu café da manhã com produtores e profissionais do agronegócio, onde o tema foi sobre os mercados de grãos e fertilizantes. O encontro foi possível gracas a parceria da Spaço Agrícola Tepeyac com a Pátria Agonegócios...

Nesta terça-feira, 25, a Spaço Agrícola e Tepeyac promoveram o primeiro workshop da 38° Expoagro e 17ª Feira da Indústria e Comércio de Goiatuba. O evento que aconteceu no Parque de Exposições contou com a presença do fitopatologista Luiz Carregal. Carregal abordou o tema "Desafios e soluções...

Esta terça-feira, 11, foi marcada por uma grande notícia envolvendo uma das principais empresas no segmento comercial de insumos e defensivos agrícola da região Sul do Estado, a Spaço Agrícola, que reuniu sócios, colaboradores, clientes e fornecedores para anunciar seu passo mais ousado desde sua fundação, em...

A Agência Goiana de Defesa Agropecuária (Agrodefesa) alerta os pecuaristas goianos sobre a necessidade de continuar cumprindo as medidas sanitárias estipuladas pelo Ministério da Agricultura e Pecuária que garantem a retirada definitiva da vacinação contra a febre aftosa. *Declaração de rebanhos* - Uma delas é a...

Nesta quarta-feira, 3, integrantes do Rotary Club de Goiatuba e da Faeg Jovem do Sindicato Rural de Goiatuba se reuniram para formalizar parceria com o objetivo de desenvolver programas que visam combater a vulnerabilidade que assola a comunidade goiatubense. O encontro aconteceu no Centro de Experiência Nutrien, onde...

A primeira edição do "Dia D Negócios" promovido pela Spaço Agrícola se encerrou nesta quinta-feira, 13, superando todas as expectativas da empresa e seus parceiros. O evento reuniu 24 indústrias do agro que produz sementes, insumos e defensivos que criaram oportunidades com ofertas especiais para os negócios...

Nesta quinta-feira, 13, durante o Dia D Negócios da Spaço Agrícola, a agrometeorologista Ludmila Camparotto, da Rural Clima afirmou aos produtores que este ano o Brasil terá uma safrinha cheia. Ludmila ressalta que a região ainda terá pelo menos duas frentes frias, gerando novas chuvas, o que...

O Departamento de Sanidade Vegetal e Insumos Agrícolas da Secretaria de Defesa Agropecuária do Ministério da Agricultura e Pecuária (Mapa) publicou o Ato n° 05 , no Diário Oficial da União desta segunda-feira (13), tornando público o registro de 22 produtos formulados, sendo 8 de baixo impacto. Essa...

Nesta sexta-feira, 16/09, equipes do COC2 / COD / DECAR / PRF / IBAMA desarticularam uma associação criminosa especializada na comercialização de Agrotóxicos sem procedência e impróprios para o consumo. Durante a Operação conjunta quatro pessoas foram presas pelos crimes de associação criminosa, crime ambiental, comercialização de...

Um olhar 360º para o agro do futuro. Essa é a proposta do Sistema Faeg/ Senar e do Sebrae Goiás, na 19ª edição da Tecnoshow Comigo, que será realizada entre os dias 04 e 08 de abril, em Rio Verde, no sudoeste goiano. Com uma programação bastante diversificada...

Canadá autorizou o início da importação de carne bovina e suína in natura do Brasil. O anúncio foi feito nesta segunda-feira (14/03) pelo Governo Federal, por meio da ministra da Agricultura, Pecuária e Abastecimento, Tereza Cristina, que está em viagem ao Canadá. Com isso, o Brasil ultrapassou a marca...

O Congresso Nacional analisou, nesta quinta-feira (17/03), 31 vetos presidenciais. Entre os itens votados, foi derrubado o veto 4/22, que institui o Programa de Venda em Balcão, com o objetivo de promover o acesso do pequeno produtor ao estoque público de milho. Com a derrubada do veto, passa...

O Índice de Insumos para a Produção de Leite Cru em Goiás - ILC, é um indicador de referência que consiste em medir a variação dos preços dos principais insumos que compõem os custos de produção dos produtores de leite cru do Estado de Goiás. No mês de...

Operações do agro no período alcançaram US$ 3,85 bilhões, com destaque para complexo soja, carnes e complexo sucroalcooleiro. No acumulado de 2021, o agronegócio respondeu por 81% do total exportado por Goiás, conforme apontam os dados divulgados pelo Comex Stat do Ministério da Economia e compilados pela Gerência...

O Brasil é um tradicional produtor de frutas cítricas. Laranjas, limões, limas e tangerinas são variedades conhecidas e que fazem parte da rotina do brasileiro, seja em consumo in natura ou em forma de sucos e sobremesas. A data foi estabelecida em 1969 para relembrar a importância desse...

Na manhã desta quinta-feira (10) a Companhia Brasileira de Abastecimento (Conab) divulgou o 9º levantamento da safra de grãos no Brasil. Este é um levantamento muito esperado, visto que apresentaria os primeiros números da quebra do milho safrinha no Brasil. Em relação à safra nacional, a produção de...

A Confederação da Agricultura e Pecuária do Brasil (CNA) entregou na quarta (19) à ministra da Agricultura, Tereza Cristina, as propostas da entidade para o Plano Agrícola e Pecuário (PAP) 2021/2022, construídas de forma conjunta com as Federações de Agricultura e Pecuária nos Estados, o Serviço Nacional de Aprendizagem...

Revisão na expectativa de produção divulgada pela Companhia Nacional de Abastecimento mostra incremento especialmente na produção de soja, trigo, sorgo e girassol, além de alto volume para a produção de milho. "Isso vem alinhado a um momento importante para o Estado, em que o Governo de Goiás trabalha em...

Alinha de crédito rural para custeio antecipado é uma importante ferramenta de financiamento que permite ao produtor rural adquirir mais cedo seus insumos agrícolas, com um melhor planejamento da safra. Com a compra antecipada, o produtor consegue melhores condições de preço e mercado. No custeio antecipado, o produtor...

Com a presença do governador Ronaldo Caiado, evento será realizado na Fazenda Brasilândia, em Montividiu, nesta quinta-feira (18/02), às 9h. Durante solenidade, instituições representativas do setor doarão R$ 1 milhão ao Estado, por meio da contratação de projetos, para execução de obras rodoviárias O Governo de Goiás, por...

Semeadura da safra de verão 2020/2021 pode ser iniciada no dia 25 deste mês O vazio sanitário da soja, medida estratégica adicional no manejo da ferrugem asiática da soja, entra na etapa final, mas precisa ser cumprido pelos agricultores até o seu término que, este ano, será no...

Conforme números publica-dos pela Secretaria de Comércio Exterior do Ministério da Economia, o resultado superavitário de US$ 6,6 bilhões da balança comercial de agosto, com crescimento de 68,9% em relação ao mesmo período do ano anterior, contou com o excelente desempenho do setor agropecuário, que foi o único a...

Os produtores rurais e micro e pequenos empresários passaram a ser o público mais beneficiado pelos recursos do Fundo Constitucional do Centro-Oeste (FCO) desde o início deste ano. De janeiro a julho, os valores destinados às empresas e produtores rurais de micro e pequeno porte somaram R$ 1,220 bilhão...

Em sessão remota, o Congresso Nacional derrubou nessa quarta-feira (12/8) vetos a três artigos da Lei do Agro (13.986/2020) que altera as regras do crédito rural. Entre os trechos retomados estão a desoneração de produtores rurais, na transação de créditos de descarbonização, o pagamento de contribuições à Seguridade Social...

Nesta etapa a orientação está voltada para o emissor de receita agronômica e para os Responsáveis Técnicos (RTs) pelos estabelecimentos comerciais. A produção de alimentos seguros, a preservação do meio ambiente e a redução de risco à saúde humana são o foco das instruções. A Agência Goiana de...

Rio Verde irá receber o segundo Centro de Excelência em Agricultura Exponencial do estado de Goiás (Ceagre), que será instalado no IF Goiano. A intenção é fortalecer a vocação agrícola do Estado com projetos de pesquisa aplicada, que são capazes de levar grandes tecnologias ao campo e agregar valor...

O Governo de Goiás, por meio da Agência Goiana de Defesa Agropecuária - Agrodefesa, volta a reforçar a importância do vazio sanitário da soja, que vai até o dia 30 de setembro. Neste período, não pode haver plantas voluntárias de soja em áreas de cultivo, como forma de reduzir...

A Declaração do Imposto sobre a Propriedade Territorial Rural (DITR), referente ao exercício de 2020, deverá ser entregue de 17 de agosto a 30 de setembro. As regras para a apresentação da DITR foram publicadas na Instrução Normativa (IN) nº 1.967/2020. (https://bit.ly/3guVAgN). A IN traz informações sobre a obrigatoriedade...
Entra em vigor no dia 3 de agosto a Instrução Normativa n° 48/2020, publicada recentemente pelo Ministério da Agricultura, Pecuária e Abastecimento (Mapa), que alinha diretrizes gerais e muda regras sobre a vigilância da febre aftosa, com vistas à continuidade da execução do Programa Nacional de Erradicação e Prevenção...